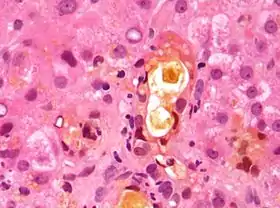

Feathery degeneration - large cells with pale flocculant cytoplasm (left-bottom and right-top). H&E stain.
In histopathology, feathery degeneration, formally feathery degeneration of hepatocytes, is a form of liver parenchymal cell (i.e. hepatocyte) death associated with cholestasis.[1]
Cells undergoing this form of cell death have a flocculant appearing cytoplasm,[2] and are larger than normal hepatocytes.
Relation to ballooning degeneration
Feathery degeneration is somewhat similar in appearance to ballooning degeneration, which is due to other causes (e.g. alcohol, obesity); it also has cytoplasmic clearing and cell swelling.
See also
Additional images
Feathery degeneration. H&E stain.
References
This article is issued from Wikipedia. The text is licensed under Creative Commons - Attribution - Sharealike. Additional terms may apply for the media files.